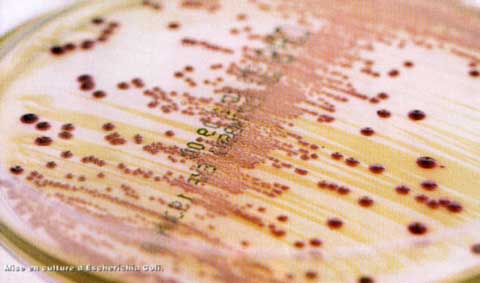

GRUPE DE ALIMENTE
GRUPE DE ALIMENTE Hotaratoare pentru o alimentatie corecta, este coexistenta tuturor factorilor nutritivi. Nu este atat de importanta valoarea nutritiva a fiecarui aliment in parte, cat mai ales valoarea nutritionala a dietei in totalitate. PrCiteste tot ... 1930 cuvinte
Dimensiune medie
- fara imagini |
 |
 |
EPIDEMIOLOGIA CANCERULUI DE SAN
EPIDEMIOLOGIA CANCERULUI DE SAN Pentru multe tari ale lumii, in cadrul acestora situandu-se si Romania localizarea mamarara este cea mai frecventa forma de cancer la femeie. Se apreciaza ca intre 6 si 10%din totalul femeilor , vor dezvolta un cCiteste tot ... 412 cuvinte
Dimensiune mica
- fara poza |
 |
 |
HIPNOTICELE (somnifere)
HIPNOTICELE (somnifere) Sunt substante care favorizeaza somnul si-i prelungesc durata. Cele mai cunoscute sunt barbituricele. Toate au actiuni comune: efect sedativ, in doze mici, hipnotic, in doze mai mari; analgetice slabe, anticonvulsivaCiteste tot ... 165 cuvinte
Dimensiune mica
- fara poza |
 |
 |
RINICHII
RINICHII Sunt organe pereche situate retroperitoneal, de o parte si de alta a coloanei vertebrale lombare. Rinichiul are forma caracteristica de boaba de fasole. Lungimea sa este de 10-12 cm, latimea de 5-6 cm si grosimea de 3-4 cm. Are o gCiteste tot ... 739 cuvinte
Dimensiune mica
+ cu imagini |
 |
 |
FIZIOLOGIA VEZICULEI BILIARE
FIZIOLOGIA VEZICULEI BILIARE 1. Secretia si motilitatea biliara Secretia biliara este un procesc activ, dependent de oxigen, care se desfasoara la nivelul celulelor hepatice. Bila este produsCiteste tot ... 1437 cuvinte
Dimensiune mica
- fara poza |
 |
 |
PREVENIREA Sl COMBATEREA TRICHINELOZEI LA OM Sl ANIMALE
PREVENIREA Sl COMBATEREA TRICHINELOZEI LA OM Sl ANIMALE Ca si in cazul altor parazitozoonoze dominante, prevenirea si combaterea trichinelozei se realizeaza printr-un complex de masuri axat pe profilaxii, si careCiteste tot ... 1458 cuvinte
Dimensiune mica
- fara poza |
 |
 |
CANCERUL BRONHOPULMONAR
CANCERUL BRONHOPULMONAR Definitie: cancerul bronhopulmonar este o tumoare maligna, cu punct de plecare bronsic. Etiopatogenie: constituie una din cele mai frecvente localizari, fiind depasita ca frecventa doar de cancerul gastric (20% din tCiteste tot ... 850 cuvinte
Dimensiune mica
- fara poza |
 |
 |
FIZIOLOGIA STOMACULUI
FIZIOLOGIA STOMACULUI Functia prinicala a stomacului este, in primul rand, de rezervor in care se acumuleaza alimentele ingerate. In stomac, alimentele sufera importante modificari fizico-chimice, care le pregateaste pentruCiteste tot ... 667 cuvinte
Dimensiune mica
- fara poza |
 |
 |
TABLOUL CLINIC - TRICHINELOZA
TABLOUL CLINIC - TRICHINELOZA 1 La om Aspectele clinice ale trichinelozei la om sunt generate de ciclul biologic si metabolismul parazitului si de raspunsul organismului gazdei parazitate. Simptomatologia variata si complexCiteste tot ... 2184 cuvinte
Dimensiune medie
- fara imagini |
 |
 |
PIELONEFRITA
PIELONEFRITA DEFINITIE: Pielonefritele sunt inflamatii acute sau cronice care afecteza tesutul interstitial renal (spatiul dintre nefroni). Importanta lor se datoreste frecventei mari si in continua crestere a infectiilor urinare (cauzaCiteste tot ... 1348 cuvinte
Dimensiune mica
+ cu imagini |
 |
 |
MEDICATIA ANTIARITMICA
MEDICATIA ANTIARITMICA Tulburarile de ritm ale inimii sunt foarte frecvente. De aici si selectionarea a numeroase droguri cu actiune antiaritmica. Chinidina, este cel mai vechi si cunoscut antiaritmic. Se foloseste in mod curent sulfatuCiteste tot ... 851 cuvinte
Dimensiune mica
- fara poza |
 |
 |
COLECISTITA CRONICA ALITIAZICA
COLECISTITA CRONICA ALITIAZICA DEFINITION AND CLINICAL FEATURES Intense epigastric or right upper quadrant pain, starting suddenly, rising in intensity over a 15-minute period, and continuing at a steady plateau for several hours beforeCiteste tot ... 1414 cuvinte
Dimensiune mica
- fara poza |
 |
 |
BOLILE APARATULUI RESPIRATOR
BOLILE APARATULUI RESPIRATOR NOTIUNI DE ANATOMIE Aparatul respirator este alcatuit din doi plamani si din conductele aeriene, formatiuni care, se divid spre periferie astfel: parenchimul pulmonar - in loK segmente (zone^, acin si aCiteste tot ... 6594 cuvinte
Dimensiune mare
- fara imagini |
 |
 |
REGIMUL IN HIPERTENSIUNEA ARTERIALA
REGIMUL IN HIPERTENSIUNEA ARTERIALA Alimente permise: - supe: de zarzavat simple sau cu adaus fainos, bors de zarzavat sau cu cartofi, supe de legume, supe de rosii, toate fara sare. - fainoase: in cantitate limitata, gris, oreCiteste tot ... 409 cuvinte
Dimensiune mica
- fara poza |
 |
 |
NOTIUNI ELEMENTARE DE DIGESTIE Sl METABOLISM
NOTIUNI ELEMENTARE DE DIGESTIE Sl METABOLISM Pentru efectuarea functiilor vitale, organismul are nevoie de energie si elemente nutritive. Acestea ii sunt furnizate de alimente. Dar principiile nutritive (factorii nutritivi) se gasesc sub formaCiteste tot ... 1545 cuvinte
Dimensiune medie
- fara imagini |
 |
 |
TRATAMENTUL COLECISTITEI CRONICE ALITIAZICE
TRATAMENTUL COLECISTITEI CRONICE ALITIAZICE Tratamentul chirurgical Solutia preferata este realizarea colecistectomiei pentru toti pacientii, exceptand cazurile care au contraindicatii pentru interventia chirurgicala. Colecistectomia lCiteste tot ... 1262 cuvinte
Dimensiune mica
+ cu imagini |
 |
 |
ACTIVITATI SI FORME DE PREVENIRE A SITUATIILOR DE URGENTA
ACTIVITATI SI FORME DE PREVENIRE A SITUATIILOR DE URGENTA Activitatile de prevenire desfasurate de Inspectoratul General pentru Situatii de Urgenta si de structurile din subordine reprezinta o componenta principala a sistemului integrat deCiteste tot ... 432 cuvinte
Dimensiune mica
- fara poza |
 |
 |
PREPARATELE TIROIDIENE SI ANTITIROIDIENE
PREPARATELE TIROIDIENE SI ANTITIROIDIENE Hormonii tiroidieni stimuleaza metabolismul tisular si servesc ca medicatie de substituire in insuficienta tiroidiana. Sunt contraindicati in insuficienta cardiaca si coronariana. Preparate: TiroidaCiteste tot ... 141 cuvinte
Dimensiune mica
- fara poza |
 |
 |
TRATAMENTUL TRICHINELOZEI
TRATAMENTUL TRICHINELOZEI Se poate afirma ca astazi, trichineloza este o boala tratabila, datorita in primul rand, progreselor din industria farmaceutica. 1. Tratamentul la om Tratamentul la om, trebuie sa fie bine gCiteste tot ... 2168 cuvinte
Dimensiune medie
- fara imagini |
 |
 |
TRANCHILIZANTELE SI NEUROLEPTICELE
TRANCHILIZANTELE SI NEUROLEPTICELE Tranchilizantele sunt substante care indeparteaza agitatia, tulburarile emotionale, tensiunea psihica. Meprobamatul reduce anxietatea, provoaca linistire, favorizeaza somnul, intareste actiunea barbituricCiteste tot ... 261 cuvinte
Dimensiune mica
- fara poza |
 |
 |
Alte pagini